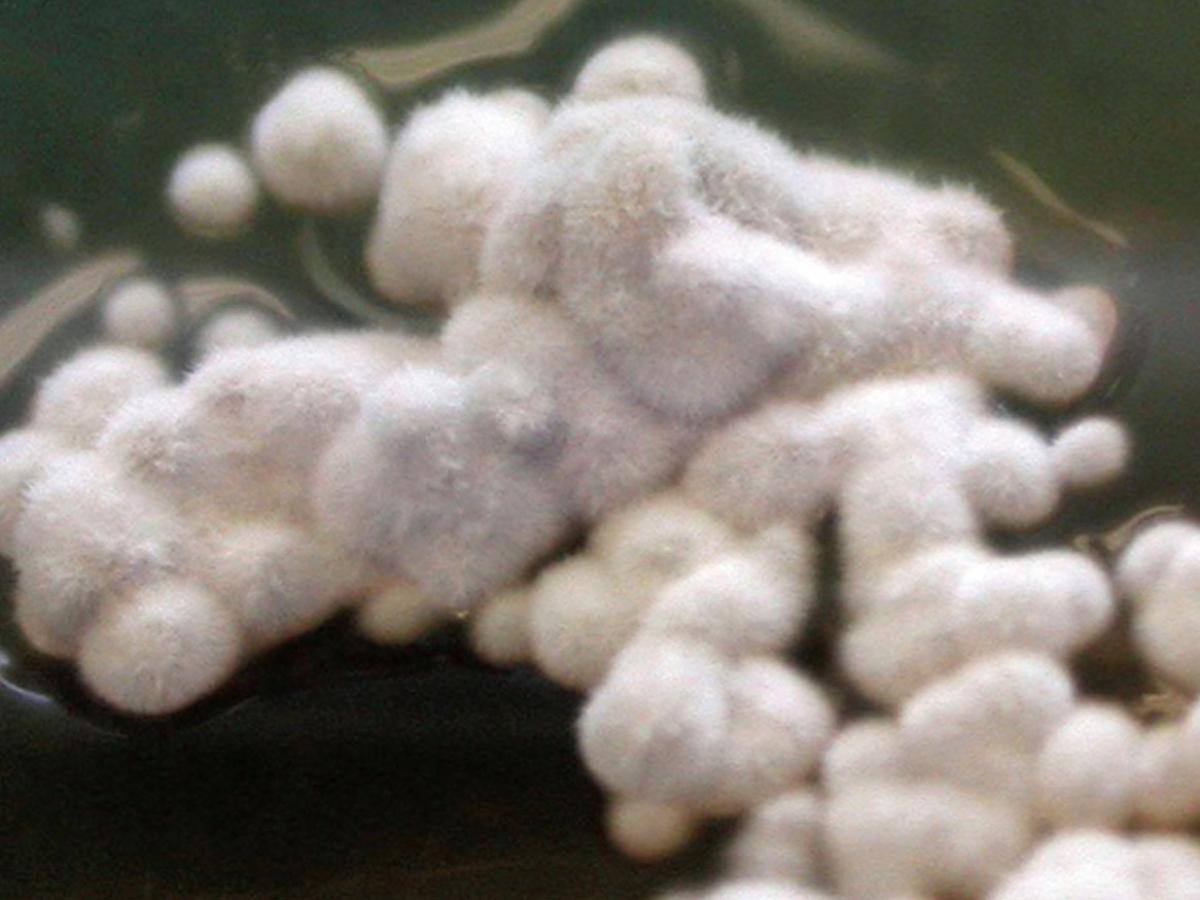
Culture

Status message
Correct! Excellent, you have really done well. Please find additional information below.
Unknown 32 = Onychocola canadensis
Culture: Colonies of O. canadensis are grow slowly and are velvety to lanose, white to yellowish, with a brownish reverse.
Microscopy: Arthroconidia are cylindrical to broadly ellipsoidal, one- or two-celled, hyaline to subhyaline, 4-16 x 2-5 µm in size, forming long chains. Older cultures may show broad, brown, rough-walled hyphae.

Key features: slow growing, white, arthroconidial mould isolated from nails.
Comment: Onychocola canadensis is an uncommon cause of distal and lateral subungual or white superficial onychomycosis. However, it may sometimes be present in an abnormal-appearing nail as an insignificant finding, not acting as a pathogen.
About Onychocola Back to virtual assessment